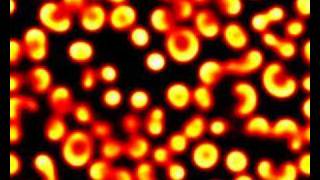

reaction diffusion spiral waves 2 video
Online izle ve mp4 mp3 formatlarinda yukle

Videonun muddeti: 1:21
reaction diffusion spiral waves 2 videosu mp4 ve mp3 yuklemek ucun hazirdir
Diqqet! Siz Mp4 yukle ve ya Mp3 yukle duymesine basdiqdan sonra eger sistem sizi reklam sehifesine atarsa o zaman derhal geri qayidib emeliyyati tekrar edin ve faylin yuklemek ucun hazir olmasini gozleyin
Videodan Mp4 Yukle
Videodan Mp3 Yukle-1
Videodan Mp3 Yukle-2
Oxshar Axtarishlar
 reaction diffusion spiral waves 2
reaction diffusion spiral waves 2 Simulating reaction diffusion model resulting in spiral waves
Simulating reaction diffusion model resulting in spiral waves Drifting Spiral Wave in the Belousov-Zhabotinsky (BZ) Reaction
Drifting Spiral Wave in the Belousov-Zhabotinsky (BZ) Reaction A theory for spiral wave drift in reaction diffusion mechanics systems
A theory for spiral wave drift in reaction diffusion mechanics systems Spiral waves in the Monodomain equation
Spiral waves in the Monodomain equation Reaction Diffusion
Reaction Diffusion FitzHugh Nagumo Model Simulation Spiral Waves
FitzHugh Nagumo Model Simulation Spiral Waves Gray-Scott reaction diffusion simulation on orbifold 4*2
Gray-Scott reaction diffusion simulation on orbifold 4*2 Persistent spiral waves in the Monodomain equation
Persistent spiral waves in the Monodomain equation
Video Mp4 Mp3Azwap.Biz
Azwap.Biz 2021-2023

reaction diffusion spiral waves 2
reaction diffusion spiral waves 2 Simulating reaction diffusion model resulting in spiral waves
Simulating reaction diffusion model resulting in spiral waves Drifting Spiral Wave in the Belousov-Zhabotinsky (BZ) Reaction
Drifting Spiral Wave in the Belousov-Zhabotinsky (BZ) Reaction A theory for spiral wave drift in reaction diffusion mechanics systems
A theory for spiral wave drift in reaction diffusion mechanics systems Spiral waves in the Monodomain equation
Spiral waves in the Monodomain equation Reaction Diffusion
Reaction Diffusion FitzHugh Nagumo Model Simulation Spiral Waves
FitzHugh Nagumo Model Simulation Spiral Waves Gray-Scott reaction diffusion simulation on orbifold 4*2
Gray-Scott reaction diffusion simulation on orbifold 4*2 Persistent spiral waves in the Monodomain equation
Persistent spiral waves in the Monodomain equation